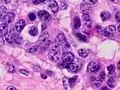
Neuroendocrine tumour of the lung with salt-and-pepper chromatin. H&E stain.

Salt-and-pepper chromatin

In pathology, salt-and-pepper chromatin, also salt-and-pepper nuclei and stippled chromatin, refers to cell nuclei that demonstrate granular chromatin (on light microscopy).[1]
Salt-and-pepper chromatin is typically seen in endocrine tumours such as medullary thyroid carcinoma, neuroendocrine tumours[2] and pheochromocytoma.[3]
Additional images
-
Neuroendocrine tumour of the lung with salt-and-pepper chromatin. H&E stain.
Neuroendocrine tumour of the lung with salt-and-pepper chromatin. H&E stain. -

-
_histopathology.jpg) A pheochromocytoma showing finely granular chromatin. H&E stain.
A pheochromocytoma showing finely granular chromatin. H&E stain. -
 Salt-and-pepper chromatin (pheochromocytoma). H&E stain.
Salt-and-pepper chromatin (pheochromocytoma). H&E stain.
References
- ^ Chetty R, Asa SL (October 2004). "Pancreatic endocrine tumour with cytoplasmic keratin whorls. Is the term "rhabdoid" appropriate?". J. Clin. Pathol. 57 (10): 1106–10. doi:10.1136/jcp.2004.018309. PMC 1770450. PMID 15452172.
- ^ Van Buren G, Rashid A, Yang AD, et al. (August 2007). "The development and characterization of a human midgut carcinoid cell line". Clin. Cancer Res. 13 (16): 4704–12. doi:10.1158/1078-0432.CCR-06-2723. PMID 17699847.
- ^ Shidham VB, Galindo LM (1999). "Pheochromocytoma. Cytologic findings on intraoperative scrape smears in five cases". Acta Cytol. 43 (2): 207–13. doi:10.1159/000330978. PMID 10097711. S2CID 232277473.
External links
- Salt-and-pepper chromatin - nature.com.
- Salt-and-pepper nucleus - upmc.edu.